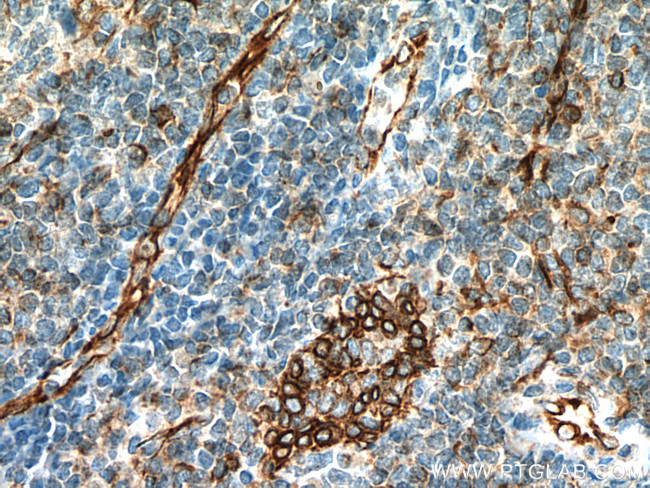
CD63 Antibody in Immunohistochemistry (Paraffin) (IHC (P))

Search
Proteintech
CD63 Monoclonal Antibody (3D4D1)
{{$productOrderCtrl.translations['antibody.pdp.commerceCard.promotion.promotions']}}
{{$productOrderCtrl.translations['antibody.pdp.commerceCard.promotion.viewpromo']}}
{{$productOrderCtrl.translations['antibody.pdp.commerceCard.promotion.promocode']}}: {{promo.promoCode}} {{promo.promoTitle}} {{promo.promoDescription}}. {{$productOrderCtrl.translations['antibody.pdp.commerceCard.promotion.learnmore']}}
产品信息
67605-1-IG
种属反应
宿主/亚型
分类
类型
克隆号
抗原
偶联物
形式
浓度
规格
纯化类型
保存液
内含物
保存条件
运输条件
产品详细信息
Aliquoting is unnecessary for -20°C storage.
靶标信息
CD63, also known as LAMP-3, is a glycoprotein belonging to the tetraspanin family, primarily located in late endosomes, lysosomes, and secretory vesicles across various cell types. It is expressed intracellularly in resting platelets and basophils, but upon activation, CD63 translocates to the plasma membrane, making it a widely used marker for basophil activation. Unlike basophils, mast cells can expose CD63 without activation. CD63 is expressed on activated platelets, monocytes, macrophages, and granulocytes, as well as endothelial cells, fibroblasts, and smooth muscle cells. It interacts with integrins (such as VLA-3 and VLA-6) and TIMP-1, playing roles in mediating allergic responses, phagocytosis, and cell migration. Additionally, CD63 is involved in the regulation of H/K-ATPase trafficking and ROMK1 channels, and serves as a T-cell costimulation molecule. CD63 expression can be used to predict prognosis in early-stage carcinomas and is identical to the melanoma-associated antigen ME491 and the platelet antigen PTLGP40. Diseases associated with CD63 dysfunction include melanoma and Hermansky-Pudlak Syndrome, highlighting its significance in both immune responses and disease processes.
仅用于科研。不用于诊断过程。未经明确授权不得转售。
生物信息学
蛋白别名: AD1 antigen; CD 63; CD63; CD63 antigen; CD63 antigen (melanoma 1 antigen); Granulophysin; LAMP-3; LAMP-3; CD63; ME491; Limp1; Lysosomal-associated membrane protein 3; Lysosome integral membrane protein 1; Melanoma-associated antigen ME491; melanoma-associated antigen MLA1; Ocular melanoma-associated antigen; OMA81H; Tetraspanin-30; Tspan-30; unnamed protein product
基因别名: AD1; CD63; HOP-26; ME491; MLA1; OMA81H; Pltgp40; TSPAN30
UniProt ID: (Human) P08962
Entrez Gene ID: (Human) 967